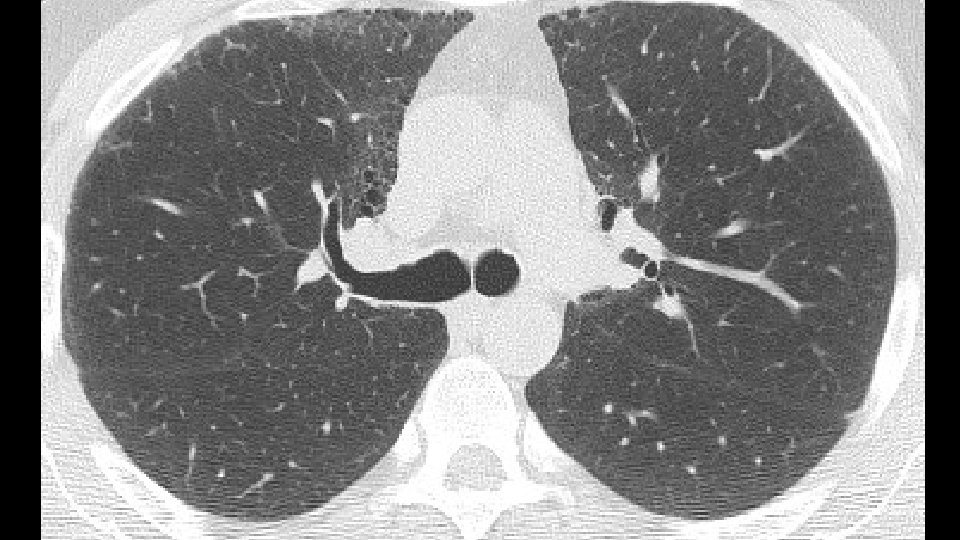
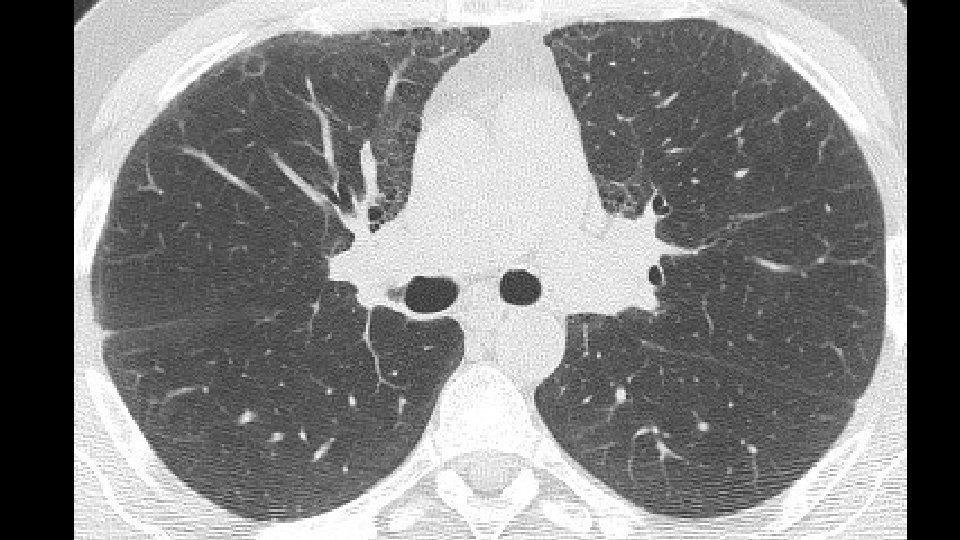

Usual interstitial pneumonia UIP Honeycombing and Traction bronchiectasis

Usual interstitial pneumonia (UIP), Honeycombing, and Traction bronchiectasis: Rad-Path exercises Thomas Colby MD Sara Piciucchi MD

Accordingly to the 2011 ATS/ERS guidelines, UIP pattern is defined by four criteria: 2. Subpleural and basal predom 1. Reticular abnormalities Definite UIP pattern 4. Absence of features listed as «inconsistent 3. Honeycombing with traction bronchiectasis

Pathologic criteria

Usual interstitial pneumonia (UIP/IPF) with Honeycombing

Usual interstitial pneumonia (UIP) Histopathology: Patchy scarring/honeycombing with active fibroblast foci Subpleural/paraseptal distribution

Honeycombing in UIP Definition: Architecturally destroyed lung tissue with abnormal airspaces lined by bronchiolar metaplasia and with thick fibrous walls 5 mm Honeycombing apparent only histologically 5 mm Honeycombing that could be apparent radiologically

Fleischner Society defines Honeycombing on CT: Clustered cystic airspaces typically of comparable diameters of 3 -10 mm, but occasionally as large as 2. 5 cm. Honeycombing is usually subpleural and characterized by well-defined walls. Watadani et al (Radiology 2013) reported that agreement among Recent literature on radiologists has a k value from 0. 4 to 0. 7 HC? Coming back to pathology. . . Mimickers: traction bronchiectasis and

What does this mean ? ? Radiologic honeycombing ≠ Pathologic honeycombing When the pathologist says “honeycombing” is present it may or may not be present radiologically. Some pathologic honeycombing manifests radiologically as ground glass change

Problem Areas in Suspected IPF: presence/absence of honeycombing • Can Radiologic evidence of UIP pattern ---no bx radiologic criteria for UIP be loosened? • Possible UIP--- bx • Inconsistent with UIP---bx (may show UIP or something else) Gruden et Al. identified the group without honeycombing and assessed the clinical and radiologic course over the time. Stable or progresive follow-up: increase of degreee of bronchiectasis and

From clinical practice……

43 years old, male non smoker Co-morbidities: psoriasis, gastritis with Helicobacter History of two years of dyspnea on exertion Lab tests: no autoimmunity

Bronchovascular ground glass attenuation + subpleural sparing D. D. f. NSIP vs inconsistent UIP (GG and bronchovascular distribution)

Patients underwent transbronchial lung biopsy with cryoprobe


Mildly fibrotic IP with possible fibroblast foci

More extensive fibrosis, relatively diffuse in distribution

Organizing pneumonia or Fibroblast foci ? ? FAVORED DIAGNOSIS: Fibrotic NSIP

ADDITIONAL HISTORY Patient underwent five cycles of cyclophosphamide (750 mg/mq) EKG and LAB tests: Normal/negative Dyspnea persisted CT scan was repeated seven months later followed by a VATS B

Increase of coarseness

Increase of cysts in the contest of reticulation a ground glass attenuation

Progressive decrease of subpleural sparing



VATS Bx: Fibrosis with honeycombing, in some areas patchy

Microscopic honeycombing, subpleural scarring

Fibroblast foci

…and still areas resembling NSIP and OP

Final diagnosis: interstitial lung disease UIP pa Why is the case important ? ? Our radiologic and histologic diagnoses are not always right and need to be correlated with patient course as it unfolds over time

Interesting cues from recent literature supporting this case

22 patients (20 men, 2 women) transplanted for pulmonary fibrosis were retrospectively CT available in 19 patients 14 (64%) were smokers Mean age at the time of trasplantation was 55 years 41% of UIP/IPF showed an extension of fibrosis around bronchovsacular bundles

Correlation between CT findings and histology on explants 1. Honeycombing: • In 18 cases of 19 CT scan available: honeycomb changes were identified and confirmed by pathology 2. NSIP and UIP: • Focal ground glass opacities in CT present in 10 cases and correlated with NSIP area and in 3 cases with acute exacerbation • NSIP areas in 60% of UIP/IPF co-existing with UIP

Retrospective study of comparison of CT scan and histologicl diagnosis in a large IPF population enrolled in three studies CT scan available for 539 subjects 1. Patients with definite UIP pattern and rad-path concordant groups were older and had lower DLCO % pred compared to those with possible. 2. No significant difference (concordant vs discordant): duration of illness, DLCO % pred, history of exposure to antigen or GERD, survival. ERJ 2016 in pre

Traction bronchiectasis in UIP pattern ____ Increasing relevance Traction bronchiectasis rarely has good radiologypathology correlation and thus the importance of its radiologic definition, recognition and diagnostic and prognostic significance

Rad: CT scan of 162 patients with diagnosis of UIP Or fibrotic NSIP scored Path: profusion of fibroblastic foci Low score of Fibrosis and FF in f. NSIP Traction bronchiectasis score 2; FF: 0. 5 High score of fibrosis and FF in UIP -RA Traction bronchiectasis score 3; FF: 3. 5 Univariate analysis: 1. Strongest correlation: between FF scores and traction bronchiectasis 2. Weaker, but significant, between FF scores and reticulation

From “traction bronchiectasis” to honeycombing in Idiopathic Pulmonary Fibrosis: a spectrum of bronchiolar remodeling also in radiology? Our hypothesis Piciucchi S, Tomassetti S, Ravaglia C, Gurioli Ch, Gurioli C, Dubini A, Carloni A, Chilosi M, Colby TV, Poletti V. Pulmonary Medicine, accepted

Key -Concepts

Role of bronchiolar epithelium in the development of UIP pattern - in IPF subjects- has been widely emphasized. Remodeling mechanism (first described by Chilosi in 2002) includes: -senescence, -alveolar stem cell exhaustion - aberrant activation of the wnt-β-catenin and hedgehog pathways Loss of cellular integrity Epigenetic reprogramming Telomere attrition Epithelial senescence Aberrant reaction of epithelial cells Migration and Proliferation of fibroblasts

If we analyze morphological aspects in light of the pathogenic events we identify some interesting key points in CT findings

1. Mechanical stress and remodeling are highest in that areas in which traction bronchiectasis and honeycombing appear. Carloni A. et Al. Journal of theoretical biology 2013 2. Most of the "scarred" tissue is in the region distal to the traction bronchiectasis, beneath the pleura and does not concentrically surround the dilated bronchi. 2007 Score 1 bronchiectasis 2014 2010 Score 3 bronchiectasis Honeycombing

3. In Nonspecific Interstitial Pneumonia (NSIP), traction bronchiectasis are completely surrounded by the fibrotic tissue Fibrotic NSIPof the years NSIP in the course a 2009 b 2013

Summary: Traction bronchiectasis observed in IPF subjects is better interpreted as resulting from bronchiolar proliferation rather than from pure mechanical traction of a single airway by scarring tissue.

UIP: culmination of the «dying back» process of acini within the secondary pulmonary lobule reversing the lung embryogenesis Kradin RL Honeycomb Lung- Time for a change Arch Honeycomb lung in IPF Pathol Lab Med 2015 Chilosi et al. Translational Research 2013 Lung development Lung aging

Thank you
- Slides: 52